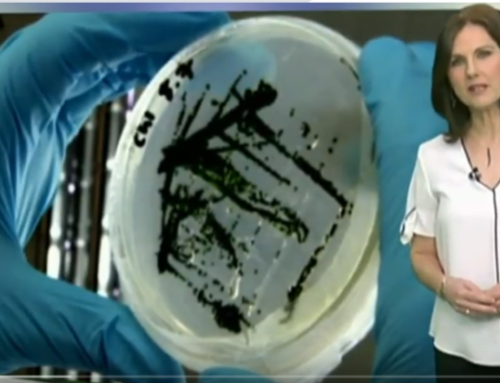
“Agrosfera” mette in evidenza i molti vantaggi dei biostimolanti AgriAlgae®

Il nostro Direttore Generale, Carlos Rodríguez-Villa, è stato intervistato lo scorso sabato 14 ottobre da María Santos, direttrice e presentatrice del Programma “En Clave Rural” (esRadio).
 María Santos, direttrice e presentatrice di “En Clave Rural”, prestigioso programma di attualità agroalimentare trasmesso da esRadio tutti i sabati dalle 7:00 alle 8:00, lo scorso sabato, 14 ottobre, ha intervistato il nostro Direttore Generale, Carlos Rodríguez-Villa.
María Santos, direttrice e presentatrice di “En Clave Rural”, prestigioso programma di attualità agroalimentare trasmesso da esRadio tutti i sabati dalle 7:00 alle 8:00, lo scorso sabato, 14 ottobre, ha intervistato il nostro Direttore Generale, Carlos Rodríguez-Villa.
L’intervista si è svolta all’interno della sezione “El Desayuno Innovador”, nella quale il programma dà visibilità settimanale alle aziende che si distinguono per il loro impegno nella ricerca e lo sviluppo nel settore agroalimentare. Durante l’intervista, Carlos Rodríguez-Villa ha catturato il pubblico con l’immenso potenziale delle microalghe e della loro applicazione in diversi settori, con particolare attenzione alla gamma di biostimolanti agricoli AgriAlgae®. Rodríguez-Villa ha presentato i vantaggi che questi prodotti possono offrire, riassunti in tre punti: un aumento della resa del raccolto, un notevole miglioramento della qualità dei frutti e un aumento della resistenza della pianta a episodi di stress. Tutto questo si traduce con una maggiore produttività per l’agricoltore.
Ha generato uno speciale interesse uno dei grandi vantaggi dell’utilizzo di AgriAlgae® sul piano ambientale, e cioè che ogni 5 litri di prodotto utilizzato, l’agricoltore evita che vengano immessi nell’atmosfera 2 kg di CO2, dato che questa è la principale sostanza nutritiva delle microalghe.
Il programma “En Clave Rural” è riuscito, durante la sua breve storia, a crearsi uno spazio nella programmazione di esRadio. Con un pubblico che cresce in maniera costante secondo i dati EGM, è diventato un punto di riferimento per il settore spagnolo. Alla guida del programma c’è la giornalista María Santos, specializzata nell’informazione agroalimentare da diversi anni, e che ha lavorato per Agrosfera su RTVE o EFE Agro, tra gli altri.
Per ascoltare l’intervista completa, clicca qui.